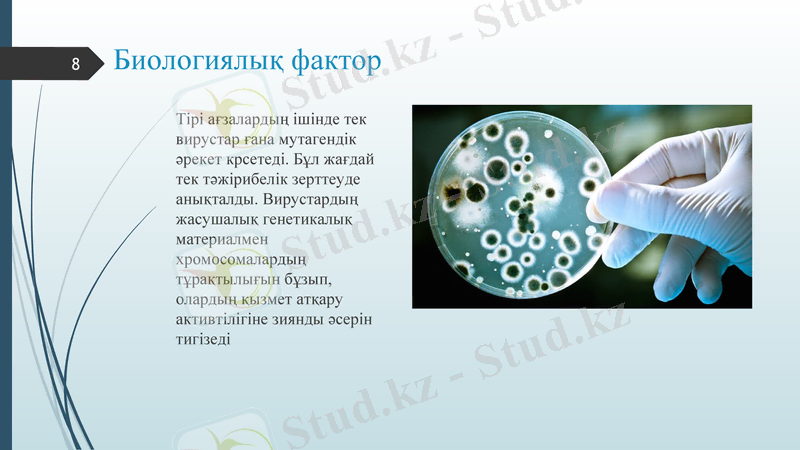
Slide 8

Тұқым қуалайтын өзгергіштік және ДНҚ репарациясының түрлері мен механизмдері



Практикалық №6.
Тұқым қуалайтынөзгергіштік. ДНҚ репарациясы
Орындаған: Камчибеков А. М.
Курс:1 курс
Мамандығы: Жалпы медицина
Тобы: 112 Б
Қабылдаған: Максутова Айдана Мадиевна
Almaty 2020
1

Жоспары:
Мутациялық өзгергіштік;
Мутагендік факторлардың жіктелуі;
Геномдық мутациялар;
Хромосомалық мутациялар;
Гендік немесе нүктелік мутациялар;
ДНҚ репарациясы;
ДНҚ репарациясының түрлері;
Қорытынды
2

Мутациялық өзгергіштік
Мутациялық өзгергіштік деп гендер мен хромосомалардағы тұрақты өзгерістер нәтижесінде қалыптасқан өгергіштікті айтады. «Мутация» терминін алғаш Г. Де Фриз «Мутациялық теория» атты классикалық еңбегінде пайдаланып, ғылыми әдебиетке енгізген. Мутацияның пайда болып, қалыптасу процесін мутагенез дейді. Мутациялық өзгерістерге себеп болатын факторлар мутагендік факторлар деп аталады.
3

Мутацияның қасиеттері
Жалпы алғанда генетикалық материалдың геномдық, хромосомалық және гендік деңгейлеріндегі кез-келген сандық немесе құрылыстық бұзылу өзгерістерін мутациялар деуге болады. Мутацияның негізгі қасиеттері:
1. Пайдаболу жиілігі төмен.
2. Мутациялардың басым көпшілігі ағзаның тіршілігіне зиянды.
3. Жаңа түзілген мутациялардың көршілігі рецессивті сипатта болады.
4

Мутагендік факторлардың жіктелуі
5

Физикалық фактор
Оларға иондаушы радиация, жоғарғы температура, оттегінің төмен парциалдық қысымы жатады.
Жақсы зерттелген физикалық мутагендік фактор - радиацияның әсері. Радиацияның өлшемі, сәулелендірі дозасы немесе ағзаның сіңірген радиоактивті заттарының мөлшерімен есептеледі.
6

Химиялық фактор
Адам денсаулығы үшін химиялық қосылыстардың мутагендік зиянды әсері иондаушы радиацияның әсерінен көптеген есе артық болып, оның өміріне қауіп туғызады.
Химиялық мутагендердің әсеріне байланысты мейоз процесі бұзылып, хромосомалардың полюстерге дұрыс ажырамауы, олардың бойында үзілулердің жүруі байқалады. ДНҚ-да нүктелік мутациялар пайда болады. Химиялық жасанды мутациялардың екі типін ажыратады:
ДНҚ-ның активсизденуі;
ДНҚ - құрылысының бұзылуы.
7
Биологиялық фактор
Тірі ағзалардың ішінде тек вирустар ғана мутагендік әрекет крсетеді. Бұл жағдай тек тәжірибелік зерттеуде анықталды. Вирустардың жасушалық генетикалық материалмен хромосомалардың тұрақтылығын бұзып, олардың қызмет атқару активтілігіне зиянды әсерін тигізеді
8

Геномдық мутациялар
Геномдық мутациялар деп хромосомалар жиынтығының немесе жеке хромосомалар санының өзгеруімен байланысты жүретін мутацияларды айтады.
9

Хромосомалық мутациялар
Хромосомалық мутациялар хромосомалар құрылысының өзгеруімен сипатталады. Типтері:
1. делециялар немесе жетіспеушілік - хромосома бөлігінің түсіп қалуы;
2. дефишенси - хромосома ұштарындағы кішігірім учаскелердің түсіп қалуы;
3. дупликациялар - хромосома бөлігінің екі еселенуі
4. инверсиялар - хромосома бөлігінің үзіліп 180° бұрылып сол хромосомадағы орнына қайта келуі.
10

Гендік немесе нүктелік мутациялар
Қандайда бір мутагендік факторлардың әрекетіне байланысты ДНҚ молекуласындағы нуклеотидтердің бір жұбы басқа жұппен алмасады. Мұның нәтижесінде ДНҚ-ның құрылысы мен қызметі өзгеріп басқа белок синтезделеді. ДНҚ тізбегіндегі бір пуриндік негіздің (аденин) екінші пуринмен (гуанин) алмасуы. Пуриндік негіздердің пиримидиндік негіздеомен алмасуы немесе керісінше алмасулары трансверсия деп аталады.
11

ДНҚ репарациясы
Репарация - тірі ағзалардың мутагендік факторлар әрекетіне байланысты ДНҚ молекуласында пайда болған бұзылуларды қалпына келтіру қасиеті. Репарация құбылысы тек ДНҚ құрылысындағы мутациялық бұзылуларды жөндеуде ғана емес, тұқым қуалайтын аурулардың қалыптасуында, ерте қартаю процесінде, жасушалардың ісіктік трансформациясында маңызды рөл атқарады.
12

ДНҚ репарацияның түрлері
Репараацияның мынандаай түрлері бар:
Жарықтық репарация (фотореактивация)
Эксцизиялық репарация
Пострепликативтік рапарация
SOS-репарация
13

Жарықтық репарация
Ультракүлгін сәулесінің әсеріне ұшыраған жасушаларда көзге көрінетін жарықтың әсерінен арнайы фотолиаза ферментінің түзілетіні анықталды. Фотодиаза ферменті мутантты ДНҚ тізбегіндегі қатар орналасқан екі пиримидиндік негіздердің арасында түзілген байланысты үзіп, ДНҚ құрылысын бастапқы қалпына келтіреді.
14

Эксцизиялық репарация
Эксцизиялық репарация мына кезеңдерден тұрады:
Мутагеннің әрекетіне байланысты ДНҚ молекуласынды тиминдік димер (Т-Т) түзіледі.
Тиминдік димер urvA және uvrB белоктарымен танылады.
ДНҚ-ға иілген пішін беру үшін және В белогы конформациясының өзгеруіне АТФ энергиясы жұмсалады.
А белогының екі молекуласы ДНҚ-дан бөлініп кетеді де, димерлік аймақта В белогының бір молекуласы ДНҚ-мен байланысқан күйде қалады.
ДНҚ молекуласына urv C белогы жалғанады
15

6. Uvr C белогы ДНҚ тізбегінің 5 штрих - ұшынан, ал uvr B белогы 3 штрих ұщынан кеседі.
7. Геликаза ферменті екі жағынан кесілген, ұзындығы 12 нуклеотидке тең ДНҚ фрагментін негізгі тізбектен бөліп ажыратады.
8. ДНҚ-полимераза I бұзылған тізбектегі түзілген бос ашық жерді бұзылмаған екінші тізбекке комплементарлы нуклеотидтермен толтыра бастайды.
- Іс жүргізу
- Автоматтандыру, Техника
- Алғашқы әскери дайындық
- Астрономия
- Ауыл шаруашылығы
- Банк ісі
- Бизнесті бағалау
- Биология
- Бухгалтерлік іс
- Валеология
- Ветеринария
- География
- Геология, Геофизика, Геодезия
- Дін
- Ет, сүт, шарап өнімдері
- Жалпы тарих
- Жер кадастрі, Жылжымайтын мүлік
- Журналистика
- Информатика
- Кеден ісі
- Маркетинг
- Математика, Геометрия
- Медицина
- Мемлекеттік басқару
- Менеджмент
- Мұнай, Газ
- Мұрағат ісі
- Мәдениеттану
- ОБЖ (Основы безопасности жизнедеятельности)
- Педагогика
- Полиграфия
- Психология
- Салық
- Саясаттану
- Сақтандыру
- Сертификаттау, стандарттау
- Социология, Демография
- Спорт
- Статистика
- Тілтану, Филология
- Тарихи тұлғалар
- Тау-кен ісі
- Транспорт
- Туризм
- Физика
- Философия
- Халықаралық қатынастар
- Химия
- Экология, Қоршаған ортаны қорғау
- Экономика
- Экономикалық география
- Электротехника
- Қазақстан тарихы
- Қаржы
- Құрылыс
- Құқық, Криминалистика
- Әдебиет
- Өнер, музыка
- Өнеркәсіп, Өндіріс
Қазақ тілінде жазылған рефераттар, курстық жұмыстар, дипломдық жұмыстар бойынша біздің қор #1 болып табылады.



Ақпарат
Қосымша
Email: info@stud.kz